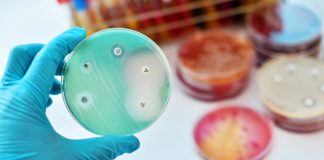
Halálos veszély leselkedik ránk: az antibiotikum-rezisztencia

További cikkek
Időjárás
Budapest
tiszta égbolt
13.7
°
C
14.5
°
12.1
°
71 %
0.5kmh
4 %
csü
21
°
pén
22
°
szo
20
°
vas
20
°
hét
13
°